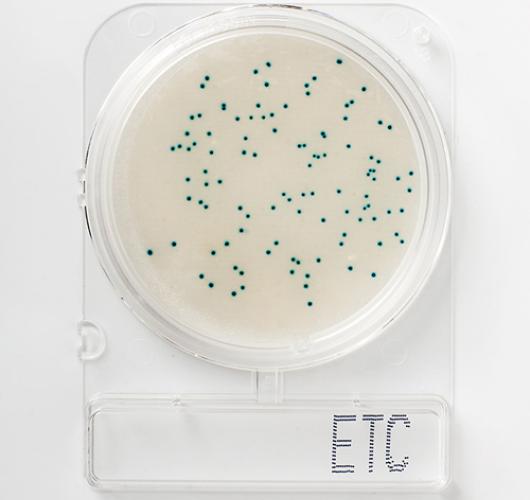

Подложки энтерококки - Compact Dry ETC
Подложки энтерококки - Compact Dry ETC
Готовая к использованию сухая хромогенная готовая среда для идентификации семейства - Энтерококки (Enterococcus).
Энтерококки широко распространены в желудочно-кишечном тракте человека и животных и могут использоваться в качестве индикатора соблюдения правил гигиены и санитарии.
Большинство видов Энтерококки считаются «низкосортными» патогенами, но некоторые условно-патогенные энтерококки могут вызывать различные инфекции. Основными патогенными видами являются Enterococcus faecalis и Enterococcus faecium.
Анализ на энтерококк является показателем качества молочных продуктов, мяса и обработанных пищевых продуктов.
Колонии энтерококков, образующиеся на хромогенных средах, приобретают светло-голубой и голубой оттенок, что облегчает их идентификацию и отличие от возможных остатков пищи.
Цвет колоний: синий/зеленый.
Температура и продолжительность инкубации: 35–37°C/20–24 часа.
Срок хранения: 12 месяцев / 5-30°С.